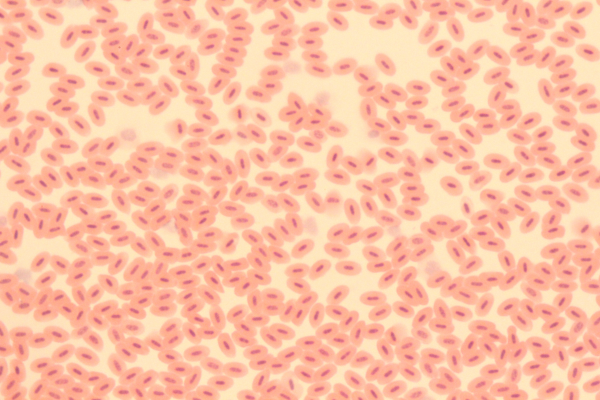
Image prise au microscope optique (pour rester cohérent avec l'époque, on trouve également des images au microscope électronique beaucoup plus détaillées) de globules rouges dans du sang de poule. On voit globalement un groupe de petites cellules avec un noyau visible à l'intérieur. Ce qui différencie le sang des oiseaux de celui des mammifères puisque, comme je l'avais indiqué dans mon thread sur les cellules, nos globules blancs à nous n'ont pas de noyau.

Ça fait un certain nombre de fois que, dans un #Vulgadredi, nous parlons de choses qu'on a découvertes grâce à des télescopes. Pour ce nouveau #VendrediVulga, nous allons pour une fois partir dans l'autre sens, et pour ça avoir recours à un autre instrument : le microscope. Ce qui devrait bien nous occuper seize pouets, comme d'habitude.
De base, les deux instruments se ressemblent beaucoup, en tout cas si l'on pense au microscope optique qui est celui que nous manipulons, notamment, au niveau de notre scolarité. Comme une lunette astronomique, un microscope est à la base essentiellement constitué de plusieurs lentilles qui permettent de diriger vers nos yeux davantage de lumière. Et comme pour les télescopes, on y a par la suite rajouté des miroirs, même si leur rôle n'est pas exactement le même.
De base, les deux instruments se ressemblent beaucoup, en tout cas si l'on pense au microscope optique qui est celui que nous manipulons, notamment, au niveau de notre scolarité. Comme une lunette astronomique, un microscope est à la base essentiellement constitué de plusieurs lentilles qui permettent de diriger vers nos yeux davantage de lumière. Et comme pour les télescopes, on y a par la suite rajouté des miroirs, même si leur rôle n'est pas exactement le même.

2/16 Comme pour la lunette astronomique, d'ailleurs, la paternité de l'instrument n'est pas clairement établie. On utilise des lentilles de verre pour dévier la lumière depuis à peu près aussi longtemps qu'on utilise du verre, mais il a fallu du temps pour avoir l'idée de, puis arriver à, combiner plusieurs lentilles pour permettre de voir des choses invisibles à l'œil nu.
Dans les deux cas, l'invention remonte probablement au début du ⅩⅦème siècle (et Galilée est parfois évoqué comme un possible inventeur, sans doute plus en raison de sa notoriété que de ses réels travaux). Quoique certaines sources mentionnent la fabrication d'un microscope dès la fin du ⅩⅤ, ce qui en ferait donc le plus ancien des deux.
Dans les deux cas, l'invention remonte probablement au début du ⅩⅦème siècle (et Galilée est parfois évoqué comme un possible inventeur, sans doute plus en raison de sa notoriété que de ses réels travaux). Quoique certaines sources mentionnent la fabrication d'un microscope dès la fin du ⅩⅤ, ce qui en ferait donc le plus ancien des deux.

3/16 Mais si le télescope a acquis une très grande notoriété dès les premières années qui ont suivi son invention, avec la découverte notamment de lunes autour de Jupiter, d'anneaux autour de Saturne et d'autres choses intrigantes dont je parlais dans ma vidéo sur Galilée, le microscope a d'abord été plus discret.
D'ailleurs, si Galilée est le premier à avoir observé les anneaux autour de Saturne, il n'a pas vraiment compris ce dont il s'agissait : ses notes parlent d'« oreilles » autour de la planète. C'est en fait un astronome de la deuxième moitié du siècle, Christiaan Huygens, qui a compris ce dont il s'agissait… et ce même Huygens, en travaillant à améliorer les instruments optiques (principalement à retirer les aberrations chromatiques), contribuera également à l'essor du microscope.
Je me répète encore mais pour le contexte astronomique de l'époque, ma vidéo sur Galilée est là : https://skeptikon.fr/videos/watch/1071c32c-e50b-4e23-9338-472f3a87a4e5
D'ailleurs, si Galilée est le premier à avoir observé les anneaux autour de Saturne, il n'a pas vraiment compris ce dont il s'agissait : ses notes parlent d'« oreilles » autour de la planète. C'est en fait un astronome de la deuxième moitié du siècle, Christiaan Huygens, qui a compris ce dont il s'agissait… et ce même Huygens, en travaillant à améliorer les instruments optiques (principalement à retirer les aberrations chromatiques), contribuera également à l'essor du microscope.
Je me répète encore mais pour le contexte astronomique de l'époque, ma vidéo sur Galilée est là : https://skeptikon.fr/videos/watch/1071c32c-e50b-4e23-9338-472f3a87a4e5
4/16 Les premières publications d'observations au microscope ont été faites au cours des années 1640, et concernaient la biologie, et en particulier l'étude des tissus vivants. On peut mentionner l'étude des yeux de mouches en 1644 ou celle du sang en 1646. Des observations de ce type ont été répétées au cours des années qui ont suivi, avec plus ou moins de succès auprès du public.
Mais c'est vers 1676 que l'instrument s'est avéré particulièrement décisif, lorsque Antoni van Leeuwenhoek, qui était parvenu à fabriquer des instruments bien plus puissants que ceux de ses contemporain, publia le résultat de ses observations : il avait été le premier à réussir à voir des micro-organismes tels que les bactéries.
Mais c'est vers 1676 que l'instrument s'est avéré particulièrement décisif, lorsque Antoni van Leeuwenhoek, qui était parvenu à fabriquer des instruments bien plus puissants que ceux de ses contemporain, publia le résultat de ses observations : il avait été le premier à réussir à voir des micro-organismes tels que les bactéries.
5/16 Il faut dire (et j'en avais parlé rapidement dans mon thread sur les cellules⁽*⁾) que les bactéries sont beaucoup plus petites que que les cellules des eucaryotes que nous sommes. Un dénommé Jan Swammerdam avait ainsi déjà observé dès 1658 nos globules rouges qui, avec leur sept micromètres de diamètre, sont parmi les plus petites cellules de notre organisme.
Les bactéries typiques, elles (même s'il en existe qui sont exceptionnellement grandes ou petites et sortent donc de cet intervalle), mesurent entre cinq micromètres et un demi-micromètre, ce qui les rend un peu plus délicates à observer. Les travaux de van Leeuwenhoek ont cependant permis de les mettre en lumière, et par là de commencer à comprendre le rôle qu'elles peuvent jouer dans nos maladies.
(∗) Qui est là, si jamais : https://fadrienn.irlnc.org/notice/AzXXsM9y1i7hIy5lqK
Les bactéries typiques, elles (même s'il en existe qui sont exceptionnellement grandes ou petites et sortent donc de cet intervalle), mesurent entre cinq micromètres et un demi-micromètre, ce qui les rend un peu plus délicates à observer. Les travaux de van Leeuwenhoek ont cependant permis de les mettre en lumière, et par là de commencer à comprendre le rôle qu'elles peuvent jouer dans nos maladies.
(∗) Qui est là, si jamais : https://fadrienn.irlnc.org/notice/AzXXsM9y1i7hIy5lqK
6/16 L'idée que les maladies pouvaient être causée par des parasites trop petits pour être visibles à l'œil nu (le mot « microscopique » n'existait évidemment pas encore à l'époque) avait été envisagée dès le siècle précédent, avant l'invention de l'instrument… mais évidemment, sans qu'il puisse encore être possible de le prouver.
Le microscope et van Leeuwenhoek ont donc permis de progresser sur ce point. Notons toutefois que d'autres parasites microscopiques, mais plus gros que les bactéries, ont d'abord occupé le devant de la scène, puisqu'il était plus facile de les observer. Ainsi, des travaux de 1687 montraient que la gale est causée par de minuscules acariens. Et je vais éviter d'illustrer ça ici parce que j'ai la flemme de CW :-)
Le microscope et van Leeuwenhoek ont donc permis de progresser sur ce point. Notons toutefois que d'autres parasites microscopiques, mais plus gros que les bactéries, ont d'abord occupé le devant de la scène, puisqu'il était plus facile de les observer. Ainsi, des travaux de 1687 montraient que la gale est causée par de minuscules acariens. Et je vais éviter d'illustrer ça ici parce que j'ai la flemme de CW :-)

7/16 Toutefois, le microscope optique n'a pas permis de trouver la cause de toutes les maladies infectieuses. Sa portée reste en effet limitée : s'il nous permet de voir les bactéries, il ne nous permet pas d'observer les virus, qui sont généralement encore plus petits, entre 10 et 400 nanomètres (là encore, il y a quelques exceptions).
En effet, en passant dans le microscope, l'onde électromagnétique qu'est la lumière visible subit un phénomène de diffraction, qui va flouter plus ou moins le résultat. L'image d'un point au microscope est donc une tache légèrement plus grande (on parle de tache d'Airy, du nom de George Biddell Airy qui a étudié ce phénomène en 1835).
La taille de cette tache dépend de la longueur d'onde utilisée, mais pour ce qui est de la notion de longueur d'onde, je vous renvoie à ma vidéo sur les couleurs : https://skeptikon.fr/w/eeace01e-b22b-4306-88c3-d9ff45585b05
En effet, en passant dans le microscope, l'onde électromagnétique qu'est la lumière visible subit un phénomène de diffraction, qui va flouter plus ou moins le résultat. L'image d'un point au microscope est donc une tache légèrement plus grande (on parle de tache d'Airy, du nom de George Biddell Airy qui a étudié ce phénomène en 1835).
La taille de cette tache dépend de la longueur d'onde utilisée, mais pour ce qui est de la notion de longueur d'onde, je vous renvoie à ma vidéo sur les couleurs : https://skeptikon.fr/w/eeace01e-b22b-4306-88c3-d9ff45585b05
8/16 Pour aller plus loin, il fallait donc utiliser autre chose que la lumière visible. Et il faudra donc attendre 1931 pour arriver à mettre au point une technologie différente, celle du microscope électronique. Le principe est ici, comme son nom l'indique, d'envoyer un faisceau d'électrons sur l'objet que l'on cherche à observer, et de capter le résultat.
À la différence d'un microscope optique, cependant, un tel appareil ne fonctionne pas avec des lentilles de verre, mais avec des « lentilles magnétiques ». J'aurais probablement un peu de mal à rentrer dans les détails techniques, mais cette technologie est le résultat de travaux théoriques ayant eu lieu dans les années 1920 et ayant entraîné également l'invention des tubes cathodiques que l'on trouve dans les oscilloscopes, ainsi que dans les télévisions avant qu'on passe aux écrans plats.
À la différence d'un microscope optique, cependant, un tel appareil ne fonctionne pas avec des lentilles de verre, mais avec des « lentilles magnétiques ». J'aurais probablement un peu de mal à rentrer dans les détails techniques, mais cette technologie est le résultat de travaux théoriques ayant eu lieu dans les années 1920 et ayant entraîné également l'invention des tubes cathodiques que l'on trouve dans les oscilloscopes, ainsi que dans les télévisions avant qu'on passe aux écrans plats.

9/16 Plusieurs technologies de microscopes électroniques ont été mises au point successivement au cours du vingtième siècle, permettant de repousser plus loin cette limite, mais par des objets toujours plus complexes et sensibles aux perturbations extérieures, nécessitant donc des isolations spécifiques. Comme on commence à sortir pas mal de mon champ de compétence, je vais donc arrêter là pour les détails techniques sur les instruments, et passer davantage à ce qu'on observe.
On peut d'ailleurs commencer à s'amuser un peu en comparant les ordres de grandeurs entre ce qu'on trouve dans l'infiniment grand et ce qu'on trouve dans l'infiniment petit. Ainsi, nos cellules, comme mentionné plus haut, mesurent quelques micromètres, soit millionièmes de mètres. Dans l'autre sens, en millions de mètres, on peut compter la distance qui nous sépare de notre Lune (environ 400 000 km, comme j'en parlais il y a deux semaines), soit finalement pas si loin que ça.
Oui, si vous avez manqué le thread d'il y a deux semaines, il est là : https://fadrienn.irlnc.org/notice/B00lUseSbXOY4KtQ8W
On peut d'ailleurs commencer à s'amuser un peu en comparant les ordres de grandeurs entre ce qu'on trouve dans l'infiniment grand et ce qu'on trouve dans l'infiniment petit. Ainsi, nos cellules, comme mentionné plus haut, mesurent quelques micromètres, soit millionièmes de mètres. Dans l'autre sens, en millions de mètres, on peut compter la distance qui nous sépare de notre Lune (environ 400 000 km, comme j'en parlais il y a deux semaines), soit finalement pas si loin que ça.
Oui, si vous avez manqué le thread d'il y a deux semaines, il est là : https://fadrienn.irlnc.org/notice/B00lUseSbXOY4KtQ8W
10/16 Allons donc voir plus loin. Nos cellules sont constituées, j'en parlais dans un thread sus-mentionné, d'un bon paquet de molécules. Ces molécules sont elles-mêmes constituées d'atomes, qui ont d'abord été considérés comme les composants élémentaires de la matière (d'où leur nom : « a-tome » en grec signifie « qui ne peut être coupé ». Comme souvent, c'était un concept que certains philosophes grecs (ici appelés « atomistes ») avaient développée et qui finalement s'avère ne pas avoir spécialement de rapport avec la vision moderne du truc.)
Les atomes sont aux limites de ce que l'on peut observer avec des microscopes électroniques, encore qu'il existe une autre technologie, la microscopie à sonde locale, qui permette de voir ça un peu mieux, mais là on commence à sortir un peu trop de mon champ de compétences. Pour descendre plus bas, il va en tout cas falloir changer pas mal de façons de faire.
Les atomes sont aux limites de ce que l'on peut observer avec des microscopes électroniques, encore qu'il existe une autre technologie, la microscopie à sonde locale, qui permette de voir ça un peu mieux, mais là on commence à sortir un peu trop de mon champ de compétences. Pour descendre plus bas, il va en tout cas falloir changer pas mal de façons de faire.

11/16 On s'est finalement rendu compte que ce nom d'« atomes » a été mal choisi, puisqu'ils sont en fait constitués de particules plus petites : des électrons, comme ceux qui servent dans les microscopes électroniques entourent un noyau lui-même constitué de protons et de neutrons. Le nombre de protons au sein d'un noyau atomique détermine l'élément chimique dont il est question, et je passe en vitesse ici parce que ce n'est pas le sujet, mais je reviendrai probablement là-dessus dans un thread dédié prochainement.
Parler de taille pour ces particules commence à poser quelque peu problème, mais on estime celle du proton à un peu moins de un femtomètre, soit 10⁻¹⁵ mètres. Ce qui fait que nous sommes légèrement plus proches d'eux, en termes d'échelles, que de la taille de notre système solaire… qui peut en fait elle aussi être évaluée de plusieurs façons, mais la limite de la zone d'influence gravitationnelle de notre étoile est estimée à grosso-modo une année-lumière, soit 10¹⁶ mètres.
Ceci dit, pour la taille des atomes, vous préférez peut-être la version de @gee, mais c'est moins rigoureux : https://grisebouille.net/le-rayon-dun-atome/
Parler de taille pour ces particules commence à poser quelque peu problème, mais on estime celle du proton à un peu moins de un femtomètre, soit 10⁻¹⁵ mètres. Ce qui fait que nous sommes légèrement plus proches d'eux, en termes d'échelles, que de la taille de notre système solaire… qui peut en fait elle aussi être évaluée de plusieurs façons, mais la limite de la zone d'influence gravitationnelle de notre étoile est estimée à grosso-modo une année-lumière, soit 10¹⁶ mètres.
Ceci dit, pour la taille des atomes, vous préférez peut-être la version de @gee, mais c'est moins rigoureux : https://grisebouille.net/le-rayon-dun-atome/
12/16 Encore une fois, donc, on semble plus proches en nombre d'ordres de grandeur de l'infiniment petit que de l'infiniment grand. Gardons quand même à l'esprit que, si on touche ici aux limites de ce que peut nous apprendre le microscope, le télescope n'arrive à nous montrer mieux que pour des objets proprement immenses : une planète comme Neptune est quatre fois plus grosse que la Terre, elle n'est située qu'à environ quatre heures-lumière de nous, et pourtant, même nos meilleurs télescopes ne nous permettent pas de voir tant de détails que ça à son sujet.
Si on arrive à voir la nébuleuse de la Lyre, par exemple, alors qu'elle est à plus de deux mille années-lumière de nous, c'est parce qu'elle a un diamètre de plus de deux années lumière. Et encore, pour en voir les couleurs, il faut faire une photo avec un très long temps de pause, avec juste son œil dans un télescope, on ne capte pas assez de lumière. Pas dit, donc, qu'on voit tellement mieux d'un côté que de l'autre.
Si on arrive à voir la nébuleuse de la Lyre, par exemple, alors qu'elle est à plus de deux mille années-lumière de nous, c'est parce qu'elle a un diamètre de plus de deux années lumière. Et encore, pour en voir les couleurs, il faut faire une photo avec un très long temps de pause, avec juste son œil dans un télescope, on ne capte pas assez de lumière. Pas dit, donc, qu'on voit tellement mieux d'un côté que de l'autre.

13/16 On peut par contre noter qu'il faut bien partir dans des directions opposées pour arriver à obtenir des données, même si c'est pour des raisons différentes : pour étudier les particules, de faibles longueurs d'ondes sont nécessaires, d'où le passage des télescopes optiques aux télescopes électroniques, comme on l'a vu plus haut.
Pour étudier les objets lointains, en revanche, du fait de l'expansion de l'univers et du red shift dont on parlait la semaine dernière, il est préférable de partir du côté des infrarouges et des ondes radios, qui sont justement caractérisées par le fait que leur longueur d'onde est beaucoup plus grande (les longueurs d'onde radio se comptent en millimètres ou en mètres).
Mais si vous avez manqué le thread de la semaine dernière, c'est là : https://fadrienn.irlnc.org/notice/B0FBBndEMU321GJpGC
Pour étudier les objets lointains, en revanche, du fait de l'expansion de l'univers et du red shift dont on parlait la semaine dernière, il est préférable de partir du côté des infrarouges et des ondes radios, qui sont justement caractérisées par le fait que leur longueur d'onde est beaucoup plus grande (les longueurs d'onde radio se comptent en millimètres ou en mètres).
Mais si vous avez manqué le thread de la semaine dernière, c'est là : https://fadrienn.irlnc.org/notice/B0FBBndEMU321GJpGC
14/16 Les protons et les neutrons ne sont eux-mêmes pas des particules élémentaires : ils sont constitués de particules plus petites, appelées quarks. Pour descendre jusqu'à ces échelles, toutefois, ce n'est plus de microscopes dont on a besoin, mais d'un accélérateur de particules.
Le principe est, comme son nom l'indique, de faire accélérer des particules, ce que l'on peut faire à l'aide de champs électriques ou magnétiques si ces particules en question sont chargées électriquement (ce qui n'est pas le cas de toutes… le neutron, comme son nom l'indique, est neutre). Il y a plusieurs applications à ces machines, mais celle qui nous intéresse ici est surtout de déclencher ensuite des collisions entre ces particules, ce qui provoque des émissions que l'on peut capter et étudier.
Le principe est, comme son nom l'indique, de faire accélérer des particules, ce que l'on peut faire à l'aide de champs électriques ou magnétiques si ces particules en question sont chargées électriquement (ce qui n'est pas le cas de toutes… le neutron, comme son nom l'indique, est neutre). Il y a plusieurs applications à ces machines, mais celle qui nous intéresse ici est surtout de déclencher ensuite des collisions entre ces particules, ce qui provoque des émissions que l'on peut capter et étudier.

- replies
- 1
- announces
- 0
- likes
- 0
15/16 Encore une fois, il faudrait entrer bien davantage dans les détails, et ça demanderait pas mal de temps et des compétences que je n'ai pas forcément. Il s'agit en tout cas d'une façon un peu plus détournée de fonctionner : on ne « voit » plus comme avec un microscope. Mais il faut dire que le monde des particules élémentaires est très particulier, de toute façon.
Quoi qu'il en soit, existe-t-il une limite théorique à nos capacités d'observation dans l'infiniment petit, un peu de la même façon que celle de l'univers observable dans l'infiniment grand ? Oui. On l'appelle la « longueur de Planck », du nom de Max Planck, qui nous a laissé plusieurs unités physiques fondamentales reliées entre elles, mais dont on parlera une prochaine fois.
Quoi qu'il en soit, existe-t-il une limite théorique à nos capacités d'observation dans l'infiniment petit, un peu de la même façon que celle de l'univers observable dans l'infiniment grand ? Oui. On l'appelle la « longueur de Planck », du nom de Max Planck, qui nous a laissé plusieurs unités physiques fondamentales reliées entre elles, mais dont on parlera une prochaine fois.

16/16 Cette longueur de Planck est vraiment minuscule : environ 1,6×10⁻³⁵ mètres. Ce qui fait que pour le coup, en ordres de grandeur, nous sommes *nettement* plus proches de la plus grande distance mesurable que de la plus petite, puisque la taille de l'univers observable, on l'a vu il y a deux semaines, est de 46,5 milliards d'années-lumière de rayon, soit 4,7×10²⁶ mètres. Nous ne sommes donc pas si petits que ça !
Mais on entrera dans les détails sur ce que c'est exactement que la longueur de Planck, et sur pourquoi on sait déjà que nos théories actuelles en physique devront tôt ou tard être remplacées, dans le thread de la semaine prochaine. À moins qu'on ne parle d'abord plus en détail des atomes et des liens qu'il peut y avoir entre la physique des particules et l'astronomie ? On verra ça la semaine prochaine. N'hésitez pas à donner votre avis !
Mais on entrera dans les détails sur ce que c'est exactement que la longueur de Planck, et sur pourquoi on sait déjà que nos théories actuelles en physique devront tôt ou tard être remplacées, dans le thread de la semaine prochaine. À moins qu'on ne parle d'abord plus en détail des atomes et des liens qu'il peut y avoir entre la physique des particules et l'astronomie ? On verra ça la semaine prochaine. N'hésitez pas à donner votre avis !
